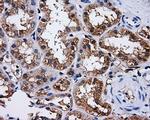
PASK Antibody in Immunohistochemistry (Paraffin) (IHC (P))

Search
OriGene
PASK Monoclonal Antibody (OTI8G9), TrueMAB™
{{$productOrderCtrl.translations['antibody.pdp.commerceCard.promotion.promotions']}}
{{$productOrderCtrl.translations['antibody.pdp.commerceCard.promotion.viewpromo']}}
{{$productOrderCtrl.translations['antibody.pdp.commerceCard.promotion.promocode']}}: {{promo.promoCode}} {{promo.promoTitle}} {{promo.promoDescription}}. {{$productOrderCtrl.translations['antibody.pdp.commerceCard.promotion.learnmore']}}
产品信息
TA500826
种属反应
宿主/亚型
分类
类型
克隆号
抗原
偶联物
形式
浓度
规格
纯化类型
保存液
内含物
保存条件
运输条件
靶标信息
PASK is an evolutionarily conserved protein present in yeast, flies, and mammals. PAS domains regulate the function of many intracellular signaling pathways in response to both extrinsic and intrinsic stimuli. It is a conserved gene product found in yeast as well as mammals. PASKIN contains two domains (PAS A and PAS B) as well as a serine/threonine kinase domain related to AMP kinases. PASKIN activity leads to decreased carbohydrate storage, as well as increased protein synthesis. PASKIN-dependent phosphorylation inhibits the activity of mammalian glycogen synthase.
仅用于科研。不用于诊断过程。未经明确授权不得转售。
篇参考文献 (0)
生物信息学
蛋白别名: KIAA0135; OTTMUSP00000024404; PAS domain-containing serine/threonine-protein kinase; PAS-kinase; per-arnt-sim (PAS) domain kinase; protein kinase; unnamed protein product
基因别名: KIAA0135; PASK; PASKIN; STK37
UniProt ID: (Human) Q96RG2
Entrez Gene ID: (Human) 23178